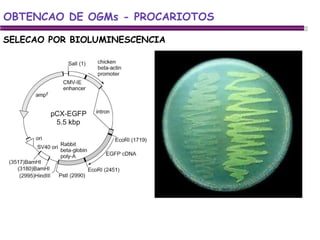
SELECAO POR BIOLUMINESCENCIA OBTENCAO DE OGMs - PROCARIOTOS

O documento aborda a engenharia genética de microrganismos, incluindo técnicas como clonagem molecular, obtenção de organismos geneticamente modificados (OGMs) e métodos de transformação. Discute também aplicações industriais dos OGMs, como bioremediação, vacinas recombinantes e produção de biocombustíveis. Além disso, detalha as ferramentas moleculares e mecanismos envolvidos nos processos de manipulação genética.